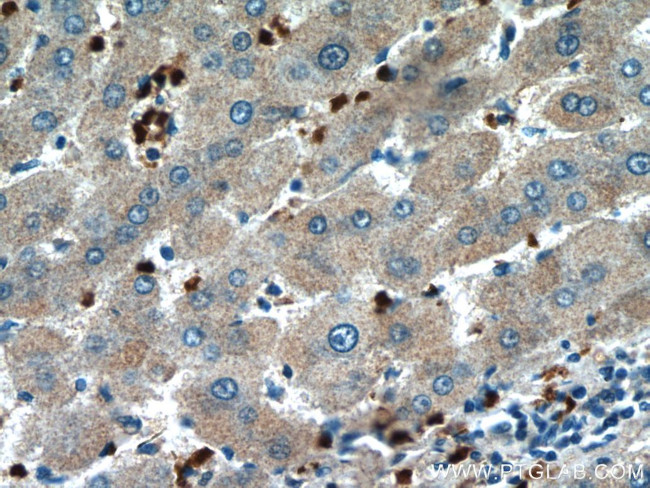
HBQ1 Antibody in Immunohistochemistry (Paraffin) (IHC (P))

Search
Proteintech
HBQ1 Polyclonal Antibody
{{$productOrderCtrl.translations['antibody.pdp.commerceCard.promotion.promotions']}}
{{$productOrderCtrl.translations['antibody.pdp.commerceCard.promotion.viewpromo']}}
{{$productOrderCtrl.translations['antibody.pdp.commerceCard.promotion.promocode']}}: {{promo.promoCode}} {{promo.promoTitle}} {{promo.promoDescription}}. {{$productOrderCtrl.translations['antibody.pdp.commerceCard.promotion.learnmore']}}
产品信息
16706-1-AP
种属反应
宿主/亚型
分类
类型
抗原
偶联物
形式
浓度
规格
纯化类型
保存液
内含物
保存条件
运输条件
产品详细信息
Immunogen sequence: MALSAEDRA LVRALWKKLG SNVGVYTTEA LERTFLAFPA TKTYFSHLDL SPGSSQVRAH GQKVADALSL AVERLDDLPH ALSALSHLHA CQLRVDPASF QLLGHCLLVT LARHYPGDFS PALQASLDKF LSHVISALVS EYR (1-142 aa encoded by BC056686)
靶标信息
Theta-globin mRNA is found in human fetal erythroid tissue but not in adult erythroid or other nonerythroid tissue. The theta-1 gene may be expressed very early in embryonic life, perhaps sometime before 5 weeks. Theta-1 is a member of the human alpha-globin gene cluster that involves five functional genes and two pseudogenes. The order of genes is: 5' - zeta - pseudozeta - mu - pseudoalpha-2 -pseudoalpha-1 - alpha-2 - alpha-1 - theta-1 - 3'. Research supports a transcriptionally active role for the gene and a functional role for the peptide in specific cells, possibly those of early erythroid tissue.
仅用于科研。不用于诊断过程。未经明确授权不得转售。
篇参考文献 (0)
生物信息学
蛋白别名: Hemoglobin subunit theta-1; Hemoglobin theta-1 chain; hemoglobin, theta 1; Theta-1-globin
基因别名: HBQ; HBQ1
UniProt ID: (Human) P09105
Entrez Gene ID: (Human) 3049